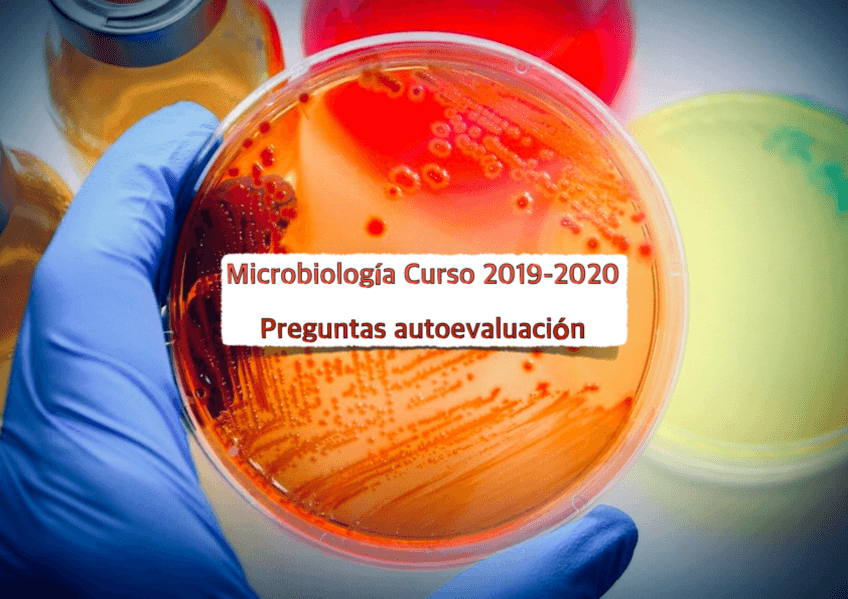

Microbiología
He publicado nuevos apuntes de 1º Microbiología: T8-Inmunoprevencion.pdf
He publicado nuevos apuntes de 1º Microbiología: T7-Fenomenos-hipersensibilidad.pdf
He publicado nuevos apuntes de 1º Microbiología: T6-Respuesta-inmunitaria-adaptativa.pdf
He publicado nuevos apuntes de 1º Microbiología: T5-Respuesta-inmunitaria-innata.pdf
He publicado nuevos apuntes de 1º Microbiología: T3-Microorg-y-las-enf-infecciosas.pdf
He publicado nuevos apuntes de 1º Microbiología: T2-Microorg-en-enfermeria.pdf
He publicado nuevos apuntes de 1º Microbiología: T7-Respuesta-inmunitaria-adaptativa240406131640.pdf
He publicado nuevos apuntes de 1º Microbiología: T6-Respuesta-inmunitaria-innata-240403190547.pdf
He publicado nuevos apuntes de 1º Microbiología: T5-Las-vacunas240330151923.pdf
He publicado nuevos apuntes de 1º Microbiología: T4-Antigeno240304140333.pdf
He publicado nuevos apuntes de 1º Microbiología: T3-El-mundo-de-los-microorg-y-su-relacion-con-enf240304112619.pdf
He publicado nuevos apuntes de 1º Microbiología: T2-Mundo-de-los-microorg-y-relacion-con-enf-infec240223194841.pdf
He publicado nuevos apuntes de 1º Microbiología: T1-Microorg-como-factor-det-de-salud240215134624.pdf
He publicado nuevos apuntes de 1º Microbiología: Preguntas vacunas SIN soluciones.pdf
He publicado nuevos examenes de 1º Microbiología: Preguntas vacunas CON soluciones.pdf
ejercicios
-
Actividades
He publicado nuevos ejercicios de 1º Microbiología: Actividades
trabajos
-
Trabajos
He publicado nuevos trabajos de 1º Microbiología: Trabajos
apuntes
-
Apuntes
He publicado nuevos apuntes de 1º Microbiología: Apuntes
He publicado nuevos apuntes de 1º Microbiología: Apuntes-Microbiologia-hasta-tema-9.pdf
He publicado nuevos examenes de 1º Microbiología: Preguntas microbiología.pdf
He publicado nuevos examenes de 1º Microbiología: Preguntas microbiología SOLUCIONES.pdf
ejercicios
-
Microbiología Actividades
He publicado nuevos ejercicios de 1º Microbiología: Microbiología Actividades
ejercicios
-
actividades MICRO
He publicado nuevos ejercicios de 1º Microbiología: actividades MICRO
He publicado nuevos trabajos de 1º Microbiología: Actividad-5Cadena-de-Infeccion.pdf
He publicado nuevos trabajos de 1º Microbiología: Actividad-4Antibioticos.pdf
He publicado nuevos trabajos de 1º Microbiología: Actividad-3Respuesta-Inmunitaria.pdf
He publicado nuevos trabajos de 1º Microbiología: Actividad-2Microbiota-de-la-Piel.pdf
He publicado nuevos trabajos de 1º Microbiología: Actividad-1Guerra-de-las-Vacunas.pdf
apuntes
-
Autoevaluaciones microbiología resueltas
He publicado nuevos apuntes de 1º Microbiología: Autoevaluaciones microbiología resueltas
apuntes
-
Trabajos microbiología resueltos
He publicado nuevos apuntes de 1º Microbiología: Trabajos microbiología resueltos
apuntes
-
Cuestionarios.
He publicado nuevos apuntes de 1º Microbiología: Cuestionarios.
He publicado nuevos examenes de 1º Microbiología: Preguntas-Examen-MICROBIOLOGIA.pdf
apuntes
-
Temario Completo Microbiología.
He publicado nuevos apuntes de 1º Microbiología: Temario Completo Microbiología.
apuntes
-
TRABAJOS MICROBIOLOGÍA
He publicado nuevos apuntes de 1º Microbiología: TRABAJOS MICROBIOLOGÍA
apuntes
-
TEMAS Y PREGUNTAS
He publicado nuevos apuntes de 1º Microbiología: TEMAS Y PREGUNTAS
apuntes
-
Trabajos
He publicado nuevos apuntes de 1º Microbiología: Trabajos
test
-
Cuestionarios 2020
He publicado nuevos test de 1º Microbiología: Cuestionarios 2020
test
-
Cuestionarios 2019
He publicado nuevos test de 1º Microbiología: Cuestionarios 2019
apuntes
-
microbiología primero enfermeria
He publicado nuevos apuntes de 1º Microbiología: microbiología primero enfermeria
apuntes
-
Microbiología
He publicado nuevos apuntes de 1º Microbiología: Microbiología
apuntes
-
Microbiología
He publicado nuevos apuntes de 1º Microbiología: Microbiología

¡Estás al día!
Has visto todos los archivos